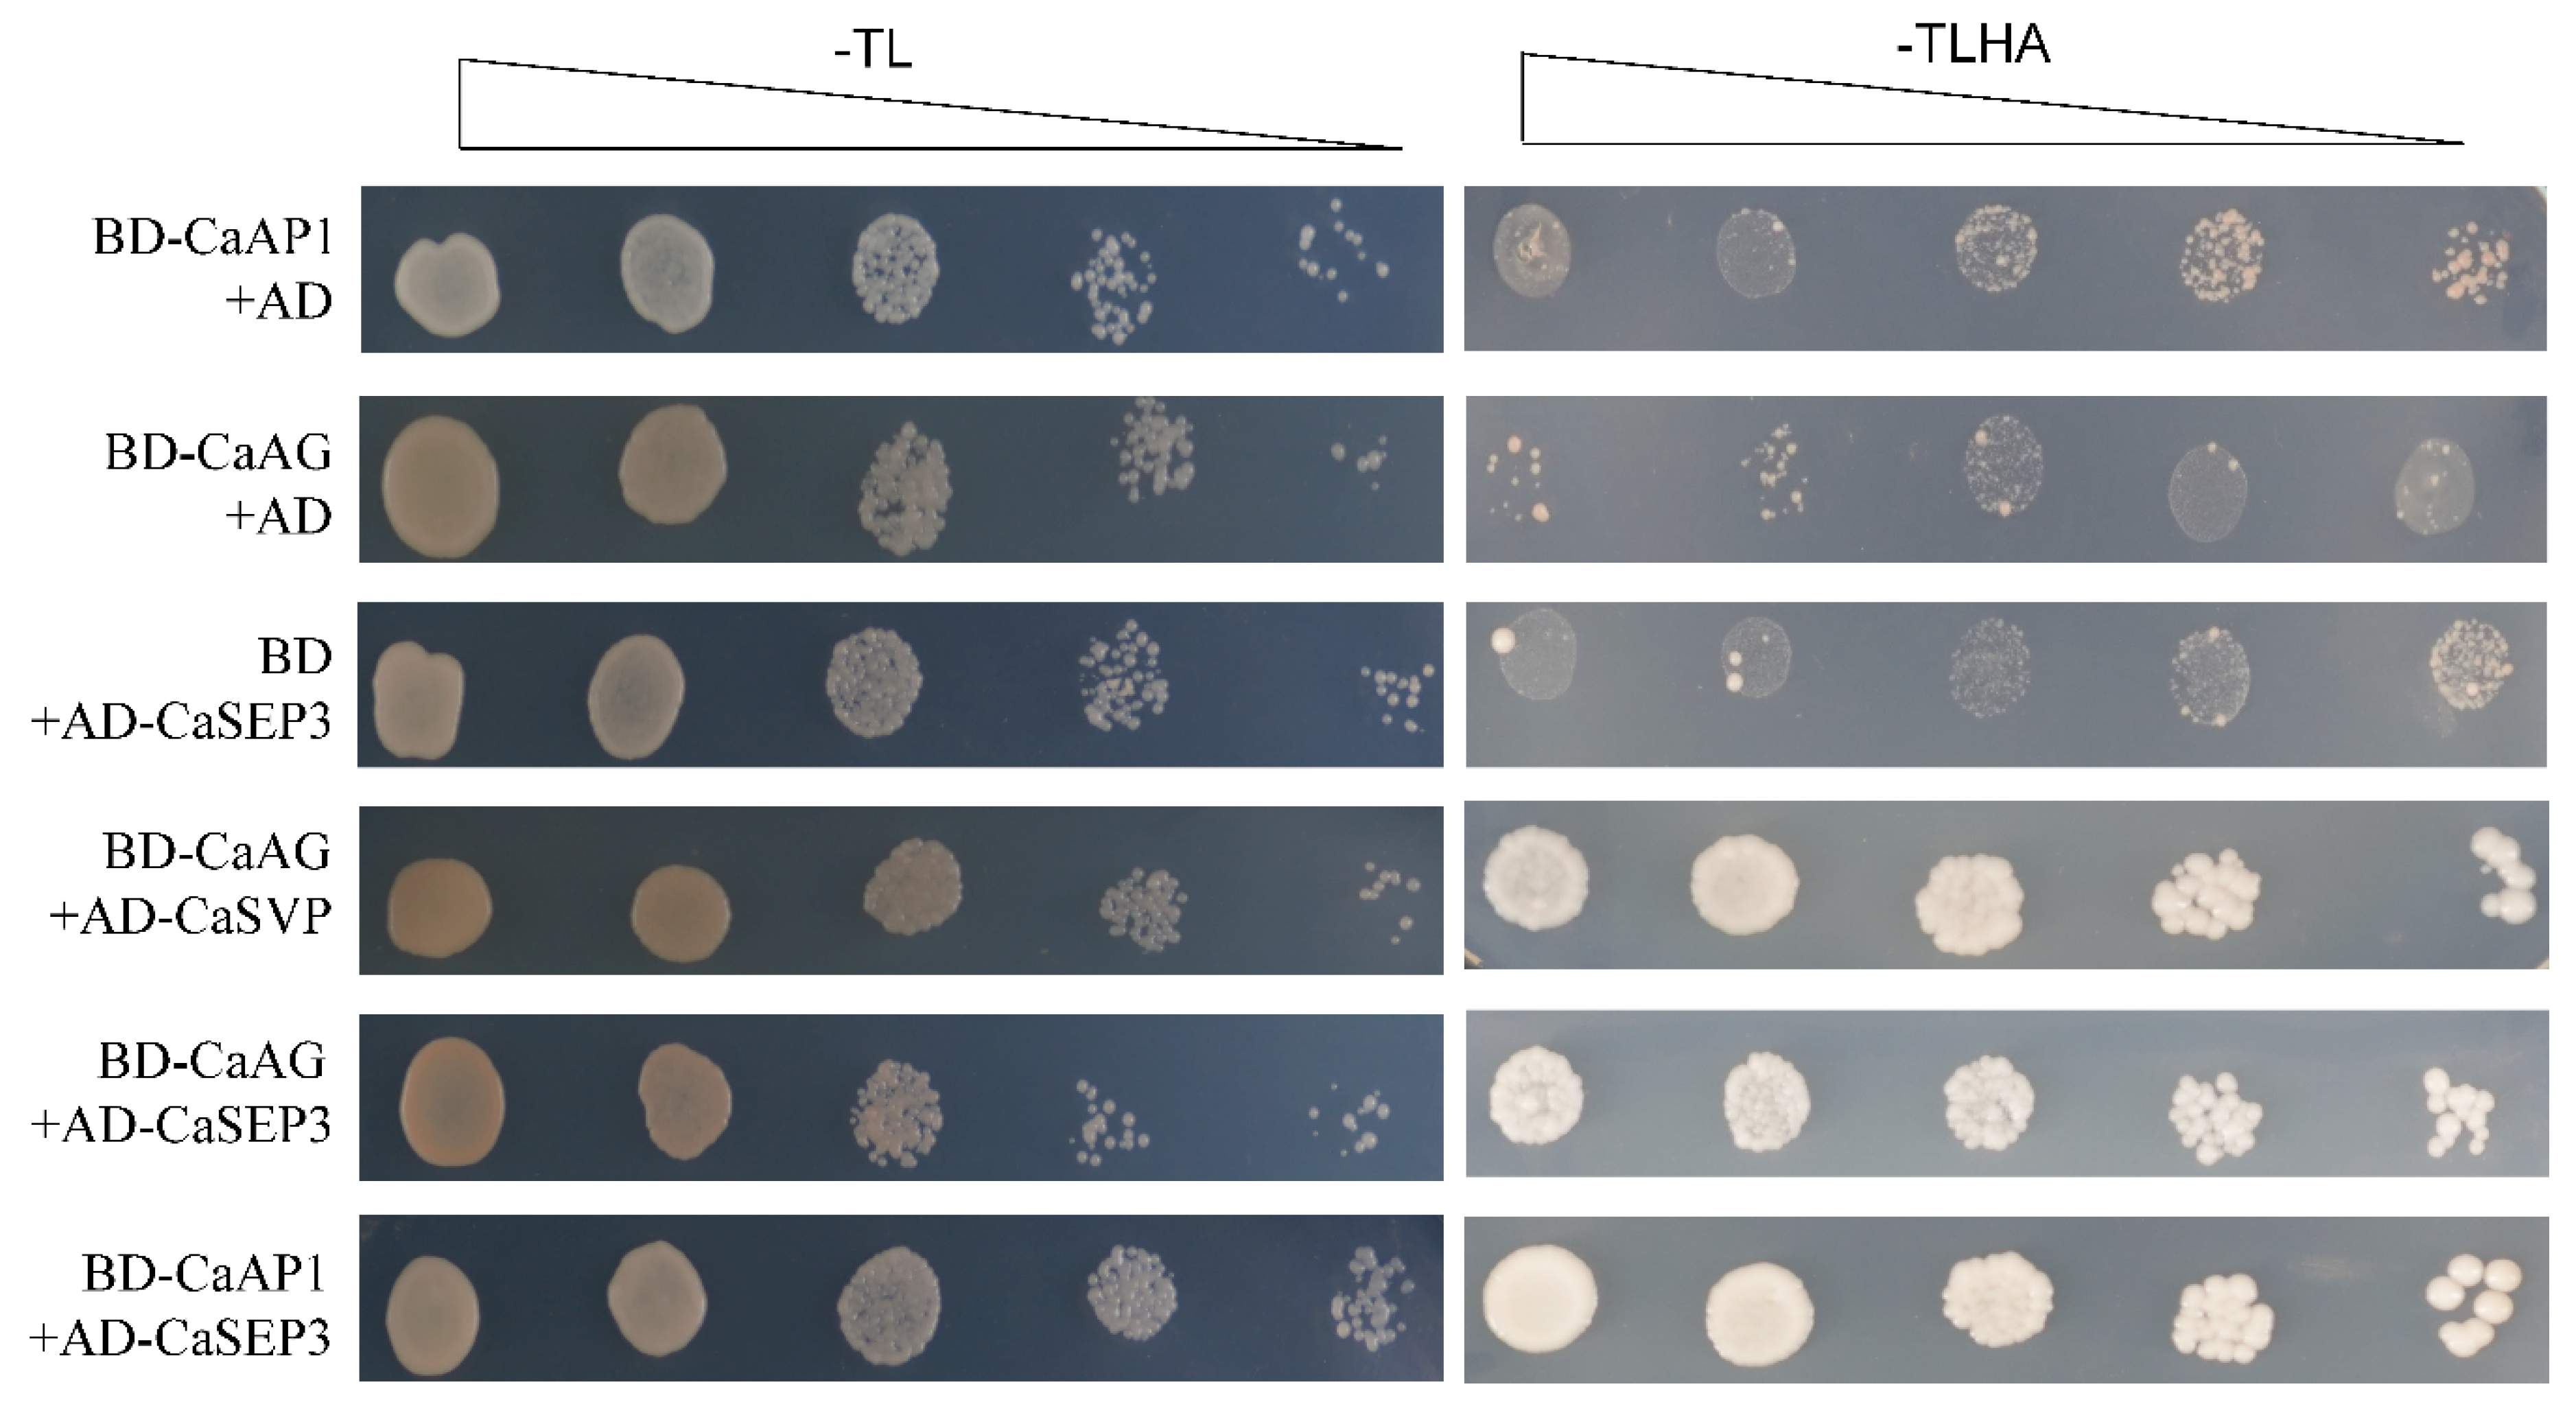
Genes 13 02047 g008 Genes 13 02047 g008

Genome-Wide Identification, Evolution, and Expression Characterization of the Pepper (Capsicum spp.) MADS-box Gene Family
Abstract
1. Introduction
2. Material and Methods
2.1. Plant Materials
2.2. Identification and Naming of MADS-box Family Genes in Three Peppers
2.3. Phylogenetic Tree Construction, Gene Structure and Protein Motif Analysis
2.4. Selective Pressure Analysis
2.5. Pepper MADS-box Gene Expression Analysis and qPCR Validation
2.6. Protein Interaction Network Prediction and Validation
3. Results
3.1. Genome-Wide Identification and Characterization of the MADS-box Transcription Factor Gene Family from Capsicum L.
3.2. Categorization, Structural Classification, and Structure of MADS-box Genes in Pepper
3.3. Phylogenetic Relationships of MADS-box Genes in Pepper
3.4. Comparative Evolutionary Relationships of Type II MADS-box Genes in Three Capsicum Speciess
3.5. Expression Characteristics of MADS-box Genes in Different Pepper Tissues
3.6. Interaction Network of Type II CaMADS Proteins
4. Discussion
Supplementary Materials
Author Contributions
Funding
Institutional Review Board Statement
Informed Consent Statement
Data Availability Statement
Conflicts of Interest
References
- Shore, P.; Sharrocks, A.D. The MADS-box Family of Transcription Factors. Eur. J. Biochem. 1995, 229, 1–13. [Google Scholar] [CrossRef] [PubMed]
- Lawton-Rauh, A.L.; Alvarez-Buylla, E.R.; Purugganan, M.D. Molecular Evolution of Flower Development. Trends Ecol. Evol. 2000, 15, 144–149. [Google Scholar] [CrossRef]
- Schwarz-Sommer, Z.; Huijser, P.; Nacken, W.; Saedler, H.; Sommer, H. Genetic Control of Flower Development by Homeotic Genes in Antirrhinum majus. Science 1990, 250, 931–936. [Google Scholar] [CrossRef] [PubMed]
- Becker, A.; Theissen, G. The Major Clades of MADS-box Genes and Their Role in The Development and Evolution of Flowering Plants. Mol. Phylogenet. Evol. 2003, 29, 464–489. [Google Scholar] [CrossRef]
- Alvarez-Buylla, E.R.; Pelaz, S.; Liljegren, S.J.; Gold, S.E.; Burgeff, C.; Ditta, G.S.; de Pouplana, L.R.; Martínez-Castilla, L.; Yanofsky, M.F. An ancestral MADS-box gene duplication occurred before the divergence of plants and animals. Proc. Natl. Acad. Sci. USA 2000, 97, 5328–5333. [Google Scholar] [CrossRef]
- Smaczniak, C.; Immink, R.; Angenent, G.C.; Kaufmann, K. Developmental and evolutionary diversity of plant MADS-domain factors: Insights from recent studies. Development 2012, 139, 3081–3098. [Google Scholar] [CrossRef]
- Parenicová, L.; de Folter, S.; Kieffer, M.; Horner, D.S.; Favalli, C.; Busscher, J.; Cook, H.E.; Ingram, R.M.; Kater, M.M.; Davies, B.; et al. Molecular and Phylogenetic Analyses of The Complete MADS-box Transcription Factor Family in Arabidopsis: New Openings to The MADS World. Plant Cell 2003, 15, 1538–1551. [Google Scholar] [CrossRef]
- Grimplet, J.; Martínez-Zapater, J.M.; Carmona, M.J. Structural and Functional Annotation of the MADS-box Transcription Factor Family in Grapevine. BMC Genom. 2016, 17, 80. [Google Scholar] [CrossRef]
- Weigel, D.; Meyerowitz, E.M. The ABCs of Floral Homeotic Genes. Cell 1994, 78, 203–209. [Google Scholar] [CrossRef]
- Theissen, G.; Kim, J.T.; Saedler, H. Classification and Phylogeny of the MADS-box Multigene Family Suggest Defined Roles of MADS-box Gene Subfamilies in The Morphological Evolution of Eukaryotes. J. Mol. Evol. 1996, 43, 484–516. [Google Scholar] [CrossRef]
- Ferrario, S.; Immink, R.G.; Angenent, G.C. Conservation and Diversity in Flower Iand. Curr. Opin. Plant Biol. 2004, 7, 84–91. [Google Scholar] [CrossRef] [PubMed]
- Irish, V.F.; Sussex, I.M. Function of The Apetala-1 Gene During Arabidopsis Floral Development. Plant Cell 1990, 2, 741–753. [Google Scholar] [PubMed]
- Jack, T.; Brockman, L.L.; Meyerowitz, E.M. The Homeotic Gene APETALA3 of Arabidopsis thaliana Encodes a MADS box and is Expressed in Petals and Stamens. Cell 1992, 68, 683–697. [Google Scholar] [CrossRef]
- Mizukami, Y.; Ma, H. Ectopic Expression of The Floral Homeotic Gene AGAMOUS in Transgenic Arabidopsis Plants Alters Floral Organ Identity. Cell 1992, 71, 119–131. [Google Scholar] [CrossRef]
- Pelaz, S.; Ditta, G.S.; Baumann, E.; Wisman, E.; Yanofsky, M.F. B and C Floral Organ Identity Functions Require SEPALLATA MADS-box genes. Nature 2000, 405, 200–203. [Google Scholar] [CrossRef]
- Favaro, R.; Pinyopich, A.; Battaglia, R.; Kooiker, M.; Borghi, L.; Ditta, G.; Yanofsky, M.F.; Kater, M.M.; Colombo, L. MADS-box Protein Complexes Control Carpel and Ovule Development in Arabidopsis. Plant Cell 2003, 15, 2603–2611. [Google Scholar] [CrossRef] [PubMed]
- Lee, S.; Jeong, D.H.; An, G. A Possible Working Mechanism for Rice SVP-Group MADS-box Proteins as Negative Regulators of Brassinosteroid Responses. Plant Signal. Behav. 2008, 3, 471–474. [Google Scholar] [CrossRef] [PubMed]
- Swiezewski, S.; Liu, F.; Magusin, A.; Dean, C. Cold-Induced Silencing by Long Antisense Transcripts of an Arabidopsis Polycomb Target. Nature 2009, 462, 799–802. [Google Scholar] [CrossRef]
- Shimada, S.; Ogawa, T.; Kitagawa, S.; Suzuki, T.; Ikari, C.; Shitsukawa, N.; Abe, T.; Kawahigashi, H.; Kikuchi, R.; Handa, H.; et al. A Genetic Network of Flowering-Time Genes in Wheat Leaves, in Which an APETALA1/FRUITFULL-Like Gene, VRN1, is Upstream of FLOWERING LOCUS T. Plant J. 2009, 58, 668–681. [Google Scholar] [CrossRef]
- Xie, Q.; Hu, Z.; Zhu, Z.; Dong, T.; Zhao, Z.; Cui, B.; Chen, G. Overexpression of a Novel MADS-box Gene SlFYFL delays Senescence, Fruit Ripening and Abscission in Tomato. Sci. Rep. 2014, 4, 4367. [Google Scholar] [CrossRef]
- Zhang, J.; Hu, Z.; Yao, Q.; Guo, X.; Nguyen, V.; Li, F.; Chen, G. A Tomato MADS-box Protein, SlCMB1, Regulates Ethylene Biosynthesis and Carotenoid Accumulation During Fruit Ripening. Sci. Rep. 2018, 8, 3413. [Google Scholar] [CrossRef] [PubMed]
- Molesini, B.; Dusi, V.; Pennisi, F.; Pandolfini, T. How Hormones and MADS-box Transcription Factors are Involved in Controlling Fruit Set and Parthenocarpy in Tomato. Genes 2020, 11, 1441. [Google Scholar] [CrossRef] [PubMed]
- Qi, X.; Liu, C.; Song, L.; Li, M. Pamads7, A MADS-box Transcription Factor, Regulates Sweet Cherry Fruit Ripening and Softening. Plant Sci. 2020, 301, 110634. [Google Scholar] [CrossRef] [PubMed]
- Roy Choudhury, S.; Roy, S.; Nag, A.; Singh, S.K.; Sengupta, D.N. Characterization of an AGAMOUS-like MADS box Protein, a Probable Constituent of Flowering and Fruit Ripening Regulatory System in Banana. PLoS ONE 2012, 7, e44361. [Google Scholar] [CrossRef] [PubMed]
- Adamski, N.M.; Simmonds, J.; Brinton, J.F.; Backhaus, A.E.; Chen, Y.; Smedley, M.; Hayta, S.; Florio, T.; Crane, P.; Scott, P.; et al. Ectopic Expression of Triticum polonicum VRT-A2 Underlies Elongated Glumes and Grains in Hexaploid Wheat in a Dosage-Dependent Manner. Plant Cell 2021, 33, 2296–2319. [Google Scholar] [CrossRef]
- Mohammadi, N.; Mehrabi, R.; Gohari, A.M.; Roostaei, M.; Goltapeh, E.M.; Safaie, N.; Kema, G.H.J. MADS-Box Transcription Factor ZtRlm1 Is Responsible for Virulence and Development of the Fungal Wheat Pathogen Zymoseptoria tritici. Front. Microbiol. 2020, 11, 1976. [Google Scholar] [CrossRef]
- Zhao, P.X.; Miao, Z.Q.; Zhang, J.; Chen, S.Y.; Liu, Q.Q.; Xiang, C.B. Arabidopsis MADS-box Factor AGL16 Negatively Regulates Drought Resistance Via Stomatal Density and Stomatal Movement. J. Exp. Bot. 2020, 71, 6092–6106. [Google Scholar] [CrossRef]
- Lai, D.; Yan, J.; He, A.; Xue, G.; Yang, H.; Feng, L.; Wei, X.; Li, L.; Xiang, D.; Ruan, J.; et al. Genome-wide Identification, Phylogenetic and Expression Pattern Analysis of MADS-box Family Genes in Foxtail Millet (Setaria italica). Sci. Rep. 2022, 12, 4979. [Google Scholar] [CrossRef]
- Theissen, G.; Saedler, H. Plant Biology. Floral Quartets. Nature 2001, 409, 469–471. [Google Scholar] [CrossRef]
- Yamaguchi, T.; Hirano, H.Y. Function and Diversification of MADS-box Genes in Rice. Sci. World J. 2006, 6, 1923–1932. [Google Scholar] [CrossRef]
- Aguilar-Meléndez, A.; Morrell, P.L.; Roose, M.L.; Kim, S.C. Genetic Diversity and Structure in Semiwild and Domesticated Chiles (Capsicum annuum; Solanaceae) from Mexico. Am. J. Bot. 2009, 96, 1190–1202. [Google Scholar] [CrossRef] [PubMed]
- Albrecht, E.; Zhang, D.; Mays, A.D.; Saftner, R.A.; Stommel, J.R. Genetic Diversity in Capsicum baccatum is Significantly Influenced by its Ecogeographical Distribution. BMC Genet. 2012, 13, 68. [Google Scholar] [CrossRef] [PubMed]
- Troconis-Torres, I.G.; Rojas-López, M.; Hernández-Rodríguez, C.; Villa-Tanaca, L.; Maldonado-Mendoza, I.E.; Dorantes-Álvarez, L.; Tellez-Medina, D.; Jaramillo-Flores, M.E. Biochemical and Molecular Analysis of Some Commercial Samples of Chilli Peppers From Mexico. J. Biomed. Biotechnol. 2012, 2012, 873090. [Google Scholar] [CrossRef] [PubMed]
- Kim, S.; Park, J.; Yeom, S.I.; Kim, Y.M.; Seo, E.; Kim, K.T.; Kim, M.S.; Lee, J.M.; Cheong, K.; Shin, H.S.; et al. New Reference Genome Sequences of Hot Pepper Reveal The Massive Evolution of Plant Disease-Resistance Genes by Retroduplication. Genome Biol. 2017, 18, 210. [Google Scholar] [CrossRef] [PubMed]
- Chen, R.; Ma, J.; Luo, D.; Hou, X.; Ma, F.; Zhang, Y.; Meng, Y.; Zhang, H.; Guo, W. CaMADS, a MADS-box transcription factor from pepper, plays an important role in the response to cold, salt, and osmotic stress. Plant Sci. 2019, 280, 164–174. [Google Scholar] [CrossRef] [PubMed]
- Sung, S.K.; Moon, Y.H.; Chung, J.E.; Lee, S.Y.; Park, H.G.; An, G. Characterization of MADS box Genes from Hot Pepper. Mol Cells. 2001, 11, 352–359. [Google Scholar]
- Qin, C.; Yu, C.; Shen, Y.; Fang, X.; Chen, L.; Min, J.; Cheng, J.; Zhao, S.; Xu, M.; Luo, Y.; et al. Whole-genome Sequencing of Cultivated and Wild Peppers Provides Insights into Capsicum Domestication and Specialization. Proc. Natl. Acad. Sci. USA 2014, 111, 5135–5140. [Google Scholar] [CrossRef]
- Liao, Y.; Wang, J.; Zhu, Z.; Liu, Y.; Chen, J.; Zhou, Y.; Liu, F.; Lei, J.; Gaut, B.S.; Cao, B.; et al. The 3D Architecture of The Pepper Genome and its Relationship to Function and Evolution. Nat. Commun. 2022, 13, 3479. [Google Scholar] [CrossRef]
- Thompson, J.D.; Gibson, T.J.; Higgins, D.G. Multiple Sequence Alignment Using ClustalW and ClustalX. Curr. Protoc. Bioinform. 2002, 2–3. [Google Scholar] [CrossRef]
- Tamura, K.; Stecher, G.; Kumar, S. MEGA11: Molecular Evolutionary Genetics Analysis Version 11. Mol. Biol. Evol. 2021, 38, 3022–3027. [Google Scholar] [CrossRef]
- Zhang, H.; Gao, S.; Lercher, M.J.; Hu, S.; Chen, W.H. Evolview, An Online Tool for Visualizing, Annotating and Managing Phylogenetic Trees. Nucleic. Acids. Res. 2012, 40, W569–W572. [Google Scholar] [CrossRef] [PubMed]
- Xu, L.; Dong, Z.; Fang, L.; Luo, Y.; Wei, Z.; Guo, H.; Zhang, G.; Gu, Y.Q.; Coleman-Derr, D.; Xia, Q.; et al. Orthovenn2: A Web Server for Whole-genome Comparison and Annotation of Orthologous Clusters Across Multiple Species. Nucleic. Acids. Res. 2019, 47, W52–W58. [Google Scholar] [CrossRef] [PubMed]
- Rozas, J.; Ferrer-Mata, A.; Sánchez-DelBarrio, J.C.; Guirao-Rico, S.; Librado, P.; Ramos-Onsins, S.E.; Sánchez-Gracia, A. Dnasp 6: DNA Sequence Polymorphism Analysis of Large Data Sets. Mol. Biol. Evol. 2017, 34, 3299–3302. [Google Scholar] [CrossRef] [PubMed]
- Yadav, C.B.; Bonthala, V.S.; Muthamilarasan, M.; Pandey, G.; Khan, Y.; Prasad, M. Genome-wide Development of Transposable Elements-based Markers in Foxtail Millet and Construction of an Integrated Database. DNA Res. 2015, 22, 79–90. [Google Scholar] [CrossRef] [PubMed]
- Chen, C.; Chen, H.; Zhang, Y.; Thomas, H.R.; Frank, M.H.; He, Y.; Xia, R. Tbtools: An Integrative Toolkit Developed for Interactive Analyses of Big Biological Data. Mol. Plant 2020, 13, 1194–1202. [Google Scholar] [CrossRef] [PubMed]
- Chen, S.; Zhou, Y.; Chen, Y.; Gu, J. fastp: An ultra-fast all-in-one FASTQ preprocessor. Bioinformatics 2018, 34, i884–i890. [Google Scholar] [CrossRef]
- Li, B.; Dewey, C.N. RSEM: Accurate Transcript Quantification From RNA-seq Data with or Without a Reference Genome. BMC Bioinformatics 2011, 12, 323. [Google Scholar] [CrossRef]
- Langmead, B.; Salzberg, S.L. Fast Gapped-Read Alignment with Bowtie 2. Nat. Methods 2012, 9, 357–359. [Google Scholar] [CrossRef]
- Wan, H.; Yuan, W.; Ruan, M.; Ye, Q.; Wang, R.; Li, Z.; Zhou, G.; Yao, Z.; Zhao, J.; Liu, S.; et al. Identification of Reference Genes for Reverse Transcription Quantitative Real-time PCR Normalization in Pepper (Capsicum annuum L.). Biochem. Biophys. Res. Commun. 2011, 416, 24–30. [Google Scholar] [CrossRef]
- Jin, Y.; Liu, F.; Huang, W.; Sun, Q.; Huang, X. Identification of Reliable Reference Genes for qRT-PCR in the Ephemeral Plant Arabidopsis pumila Based on Full-length Transcriptome Data. Sci. Rep. 2019, 9, 8408. [Google Scholar] [CrossRef]
- Su, G.; Morris, J.H.; Demchak, B.; Bader, G.D. Biological Network Exploration with Cytoscape 3. Curr. Protoc. Bioinform. 2014, 47, 8.13.1–8.13.24. [Google Scholar] [CrossRef]
- Si, Z.; Liu, H.; Zhu, J.; Chen, J.; Wang, Q.; Fang, L.; Gao, F.; Tian, Y.; Chen, Y.; Chang, L.; et al. Mutation of SELF-PRUNING Homologs in Cotton Promotes Short-Branching Plant Architecture. J. Exp. Bot. 2018, 5269, 2543–2553. [Google Scholar] [CrossRef] [PubMed]
- Liu, H.; Huang, X.Z.; Ma, B.; Zhang, T.T.; Sang, N.; Lu, Z.; Zhu, J.B. Components and Functional Diversification of Florigen Activation Complexes in Cotton. Plant Cell Physiol. 2021, 62, 1542–1555. [Google Scholar] [CrossRef] [PubMed]
- Mandel, M.A.; Yanofsky, M.F. A Gene Triggering Flower Formation in Arabidopsis. Nature 1995, 377, 522–524. [Google Scholar] [CrossRef] [PubMed]
- Smaczniak, C.; Immink, R.G.; Muiño, J.M.; Blanvillain, R.; Busscher, M.; Busscher-Lange, J.; Dinh, Q.D.; Liu, S.; Westphal, A.H.; Boeren, S.; et al. Characterization of MADS-domain Transcription Factor Complexes in Arabidopsis Flower Development. Proc. Natl. Acad. Sci. USA 2012, 109, 1560–1565. [Google Scholar] [CrossRef] [PubMed]
- Castillejo, C.; Romera-Branchat, M.; Pelaz, S. A New Role of The Arabidopsis SEPALLATA3 Gene Revealed by its Constitutive Expression. Plant J. 2005, 43, 586–596. [Google Scholar] [CrossRef] [PubMed]
- Cannon, S.B.; Mitra, A.; Baumgarten, A.; Young, N.D.; May, G. The Roles of Segmental and Tandem Gene Duplication in the Evolution of Large Gene Families in Arabidopsis thaliana. BMC Plant Biol. 2004, 4, 10. [Google Scholar] [CrossRef]
- Kim, S.; Koh, J.; Yoo, M.J.; Kong, H.; Hu, Y.; Ma, H.; Soltis, P.S.; Soltis, D.E. Expression of Floral MADS-box Genes in Basal Angiosperms: Implications for the Evolution of Floral Regulators. Plant J. 2005, 43, 724–744. [Google Scholar] [CrossRef]
- Zhang, Z.B.; Jin, Y.J.; Wan, H.H.; Cheng, L.; Feng, Z.G. Genome-wide Identification and Expression Analysis of the MADS-box Transcription Factor Family in Camellia sinensis. J. Appl. Genet. 2021, 62, 249–264. [Google Scholar] [CrossRef]
- Lin, Z.; Cao, D.; Damaris, R.N.; Yang, P. Genome-wide Identification of MADS-box Gene Family in Sacred Lotus (Nelumbo nucifera) Identifies a SEPALLATA Homolog Gene Involved in Floral Development. BMC Plant Biol. 2020, 20, 497. [Google Scholar] [CrossRef]
- Tang, W.; Tu, Y.; Cheng, X.; Zhang, L.; Meng, H.; Zhao, X.; Zhang, W.; He, B. Genome-wide Identification and Expression Profile of the MADS-box Gene Family in Erigeron breviscapus. PLoS ONE 2019, 14, e0226599. [Google Scholar] [CrossRef] [PubMed]
- Wang, Y.; Zhang, J.; Hu, Z.; Guo, X.; Tian, S.; Chen, G. Genome-wide Analysis of the MADS-box Transcription Factor Family in Solanum lycopersicum. Int. J. Mol. Sci. 2019, 20, 2961. [Google Scholar] [CrossRef] [PubMed]
- Zhao, H.B.; Jia, H.M.; Wang, Y.; Wang, G.Y.; Zhou, C.C.; Jia, H.J.; Gao, Z.S. Genome-wide Identification and Analysis of the MADS-box Gene Family and its Potential Role in Fruit Development and Ripening in Red Bayberry (Morella rubra). Gene 2019, 717, 144045. [Google Scholar] [CrossRef] [PubMed]
- Zhang, Y.; Tang, D.; Lin, X.; Ding, M.; Tong, Z. Genome-wide Identification of MADS-box Family Genes in Moso Bamboo (Phyllostachys edulis) and a Functional Analysis of Pemads5 in Flowering. BMC Plant Biol. 2018, 18, 176. [Google Scholar] [CrossRef]
- Ma, J.; Yang, Y.; Luo, W.; Yang, C.; Ding, P.; Liu, Y.; Qiao, L.; Chang, Z.; Geng, H.; Wang, P.; et al. Genome-wide Identification and Analysis of the MADS-box Gene Family in Bread Wheat (Triticum aestivum L.). PLoS ONE 2017, 12, e0181443. [Google Scholar] [CrossRef]
- Zhang, L.; Zhao, J.; Feng, C.; Liu, M.; Wang, J.; Hu, Y. Genome-Wide Identification, Characterization of the MADS-box Gene Family in Chinese Jujube and their Involvement in Flower Development. Sci. Rep. 2017, 7, 1025. [Google Scholar] [CrossRef]
- Li, C.; Wang, Y.; Xu, L.; Nie, S.; Chen, Y.; Liang, D.; Sun, X.; Karanja, B.K.; Luo, X.; Liu, L. Genome-wide Characterization of the MADS-box Gene Family in Radish (Raphanus sativus L.) and Assessment of its Roles in Flowering and Floral Organogenesis. Front. Plant Sci. 2016, 7, 1390. [Google Scholar] [CrossRef]
- Ning, K.; Han, Y.; Chen, Z.; Luo, C.; Wang, S.; Zhang, W.; Li, L.; Zhang, X.; Fan, S.; Wang, Q. Genome-Wide Analysis of MADS-box Family Genes During Flower Development in Lettuce. Plant Cell Environ. 2019, 42, 1868–1881. [Google Scholar] [CrossRef]
- Duan, W.; Song, X.; Liu, T.; Huang, Z.; Ren, J.; Hou, X.; Li, Y. Genome-Wide Analysis of the MADS-box Gene Family in Brassica rapa (Chinese cabbage). Mol. Genet. Genomics 2015, 290, 239–255. [Google Scholar] [CrossRef]
- Alhindi, T.; Al-Abdallat, A.M. Genome-Wide Identification and Analysis of the MADS-box Gene Family in American Beautyberry (Callicarpa americana). Plants 2021, 10, 1805. [Google Scholar] [CrossRef]
- Won, S.Y.; Jung, J.A.; Kim, J.S. Genome-wide Analysis of the MADS-box Gene Family in Chrysanthemum. Comput. Biol. Chem. 2021, 90, 107424. [Google Scholar] [CrossRef] [PubMed]
- Wang, R.; Ming, M.; Li, J.; Shi, D.; Qiao, X.; Li, L.; Zhang, S.; Wu, J. Genome-wide Identification of the MADS-box Transcription Factor Family in Pear (Pyrus bretschneideri) Reveals Evolution and Functional Divergence. PeerJ 2017, 5, e3776. [Google Scholar] [CrossRef] [PubMed]
- Riechmann, J.L.; Krizek, B.A.; Meyerowitz, E.M. Dimerization Specificity of Arabidopsis MADS Domain Homeotic Proteins APETALA1, APETALA3, PISTILLATA, and AGAMOUS. Proc. Natl. Acad. Sci. USA 1996, 93, 4793–4798. [Google Scholar] [CrossRef] [PubMed]
- Ng, M.; Yanofsky, M.F. Function and Evolution of the Plant MADS-box Gene Family. Nat. Rev. Genet 2001, 2, 186–195. [Google Scholar] [CrossRef] [PubMed]
- Schilling, S.; Pan, S.; Kennedy, A.; Melzer, R. MADS-box Genes and Crop Domestication: The Jack of all Traits. J. Exp. Bot. 2018, 69, 1447–1469. [Google Scholar] [CrossRef]
- Honma, T.; Goto, K. Complexes of MADS-box Proteins are Sufficient to Convert Leaves into Floral Organs. Nature 2001, 409, 525–529. [Google Scholar] [CrossRef]

Publisher’s Note: MDPI stays neutral with regard to jurisdictional claims in published maps and institutional affiliations. |
© 2022 by the authors. Licensee MDPI, Basel, Switzerland. This article is an open access article distributed under the terms and conditions of the Creative Commons Attribution (CC BY) license (https://creativecommons.org/licenses/by/4.0/).
Share and Cite
Gan, Z.; Wu, X.; Biahomba, S.A.M.; Feng, T.; Lu, X.; Hu, N.; Li, R.; Huang, X. Genome-Wide Identification, Evolution, and Expression Characterization of the Pepper (Capsicum spp.) MADS-box Gene Family. Genes 2022, 13, 2047. https://doi.org/10.3390/genes13112047
Gan Z, Wu X, Biahomba SAM, Feng T, Lu X, Hu N, Li R, Huang X. Genome-Wide Identification, Evolution, and Expression Characterization of the Pepper (Capsicum spp.) MADS-box Gene Family. Genes. 2022; 13(11):2047. https://doi.org/10.3390/genes13112047
Chicago/Turabian StyleGan, Zhicheng, Xingxing Wu, Sage Arnaud Missamou Biahomba, Tingting Feng, Xiaoming Lu, Nengbing Hu, Ruining Li, and Xianzhong Huang. 2022. "Genome-Wide Identification, Evolution, and Expression Characterization of the Pepper (Capsicum spp.) MADS-box Gene Family" Genes 13, no. 11: 2047. https://doi.org/10.3390/genes13112047
APA StyleGan, Z., Wu, X., Biahomba, S. A. M., Feng, T., Lu, X., Hu, N., Li, R., & Huang, X. (2022). Genome-Wide Identification, Evolution, and Expression Characterization of the Pepper (Capsicum spp.) MADS-box Gene Family. Genes, 13(11), 2047. https://doi.org/10.3390/genes13112047

